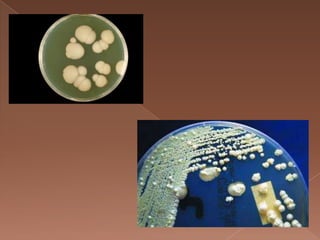

Candida albicans es un hongo comensal que puede causar infecciones como candidiasis. Se analiza mediante observación microscópica de muestras y cultivo en medios selectivos, mostrando levaduras ovaladas de 3-5 micras. Es sensible a antifúngicos como fluconazol.